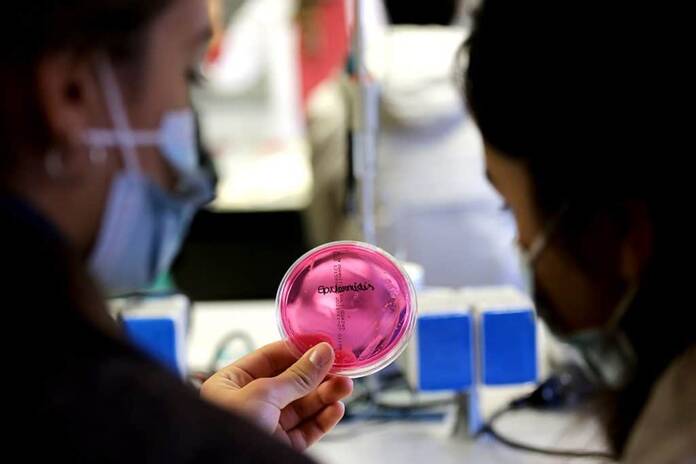

La Universidad CEU San Pablo apuesta por la divulgación científica. Para ello, el centro madrileño ha puesto en marcha la XXI edición de la Semana de la Ciencia y la Innovación organizada por la Fundación para el Conocimiento Madri+d a la que han asistido más de 1.000 participantes. Gracias a esta iniciativa, los Campus de Moncloa y Montepríncipe se han inundado de ciencia con 26 actividades organizadas en Universidad en las que han participado 70 profesores y 15 expertos externos.
Esta semana dedicada a la ciencia se ha celebrado del 1 al 14 de noviembre y ha sido todo un éxito. Los asistentes a las aulas y los laboratorios han aprendido de primera mano sobre retos y técnicas científicas actuales; desde la elaboración de una aspirina o los métodos experimentales que se emplean para la valoración de los efectos producidos por las drogas de abuso. Asimismo, también se han realizado actividades sobre tecnología cosmética y cosmocéutica decorativa para el tratamiento de cicatrices.
Asimismo, gracias a la Universidad CEU San Pablo la ciencia también ha inundado el centro de Madrid. Los asistentes ha podido realizar un recorrido desde la Plaza de Oriente, siguiendo las huellas del agua para comprender su papel en la configuración del espacio urbano. También se ha realizado un taller de dibujo sobre el monumento del Ángel Caído del Parque del Retiro.
Los asistentes ha podido realizar un recorrido siguiendo las huellas del agua para comprender su papel en la configuración del espacio urbano
Aunque se ha recuperado la actividad presencial, el centro universitario madrileño también ha apostado por el formato online para esta semana dedicada a la ciencia y a la innovación. Los alumnos han podido participar en itinerarios virtuales como el de FabLab de impresión en 3D o un taller sobre las nuevas técnicas de innovación docente con altavoces inteligentes.
La ciencia y la innovación aplicada a la salud también han sido protagonistas en la Semana de la Ciencia y la Innovación de la Universidad. Las actividades han permitido conocer los secretos de la telemedicina en fisioterapia respiratoria, las herramientas para ayudar a las personas mayores y sus cuidadores a afrontar el coronavirus o las posibilidades que brinda la música en las relaciones familiares.
80 AÑOS DE TRADICIÓN DOCENTE
La Universidad CEU San Pablo se trata de uno de los centros de educación superior privado más emblemático de la ciudad de Madrid. Con sede en la calle Julián Romea 23, la Fundación CEU San Pablo cuenta con más de 80 años de tradición docente que ahonda en los conocimientos científicos desde el prisma del humanismo cristiano.
Actualmente, el centro cuenta con cinco facultades y una escuela politécnica superior en la que se imparten grados, másteres, doctorados y títulos propios de la Universidad. Esta formación está dotada de una dimensión internacional ya que los alumnos pueden optar a programas en el extranjero. Así, los alumnos de la Universidad CEU San Pablo pueden desarrollar al máximo su carrera internacional complementando los estudios de grado con un certificado académico extranjero además de poder optar a becas gubernamentales en el extranjero como el programa ERASMUS+.
Pero si algo destaca de la Universidad CEU San Pablo es la alta tasa de inserción laboral que tienen los alumnos egresados del centro. Según datos de la Universidad, el 94% de los alumnos encuentra trabajo tras graduarse en el CEU. Asimismo, el centro universitario madrileño cuenta con 9.000 convenios con empresas para la realización de prácticas u otras actividades.








